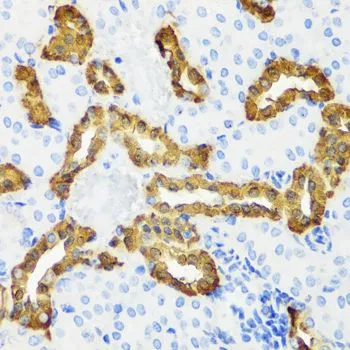

WB analysis of various sample lysates using GTX66044 Calbindin antibody. Dilution : 1:1000 Loading : 25microg per lane
Calbindin antibody
GTX66044
ApplicationsWestern Blot, ImmunoHistoChemistry, ImmunoHistoChemistry Paraffin
Product group Antibodies
ReactivityHuman, Mouse, Rat
TargetCALB1
Overview
- SupplierGeneTex
- Product NameCalbindin antibody
- Delivery Days Customer9
- Application Supplier NoteWB: 1:500 - 1:2000. IHC-P: 1:50 - 1:100. *Optimal dilutions/concentrations should be determined by the researcher.Not tested in other applications.
- ApplicationsWestern Blot, ImmunoHistoChemistry, ImmunoHistoChemistry Paraffin
- CertificationResearch Use Only
- ClonalityPolyclonal
- ConjugateUnconjugated
- Gene ID793
- Target nameCALB1
- Target descriptioncalbindin 1
- Target synonymsCALB, D-28K, calbindin, RTVL-H protein, calbindin 1, (28kD), calbindin 1, 28kDa, calbindin 27, calbindin D28, calbindin-D28k, vitamin D-dependent calcium-binding protein, avian-type
- HostRabbit
- IsotypeIgG
- Protein IDP05937
- Protein NameCalbindin
- Scientific DescriptionThe protein encoded by this gene is a member of the calcium-binding protein superfamily that includes calmodulin and troponin C. Originally described as a 27 kDa protein, it is now known to be a 28 kDa protein. It contains four active calcium-binding domains, and has two modified domains that are thought to have lost their calcium binding capability. This protein is thought to buffer entry of calcium upon stimulation of glutamate receptors. Depletion of this protein was noted in patients with Huntington disease. [provided by RefSeq, Jan 2015]
- ReactivityHuman, Mouse, Rat
- Storage Instruction-20°C or -80°C,2°C to 8°C
- UNSPSC12352203